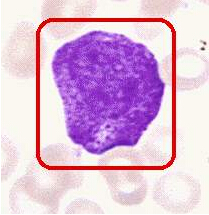

出国留学网专题频道出货检验副主管栏目,提供与出货检验副主管相关的所有资讯,希望我们所做的能让您感到满意!
03-19
对于出货检验工作,你有怎样的了解?来了解一下,并说说你的感受吧!下面是由出国留学网小编为大家整理的“关于出货检验工作内容总结”,仅供参考,欢迎大家阅读。
一、出货检验员岗位职责
1、严格执行部门制度、SIP等管理体系文件及会议决议。
2、按照出货计划,全程监控出货过程和成品质量,填写相关报表。
3、检验出库产品质量、监督仓库装卸操作规范性,并监督仓库按先进先出原则出货;
4、负责收集仓库三防设施保障状况;
5、负责不合格品的标识与隔离,并跟踪处理;
6、参与退货的处理;
7、负责登记出库产品批号,确保产品出厂的可追溯。
8、填写、收集、整理车间相关质量报表;
9、每天对产品出货数量和批号进行统计、分析、汇总。
10、每日上交《工作日报表》,每周交工作总结,每月交月工作总结;
11、参加质检部的品质例会;
12、向外包装质检员反应成品异常情况;
13、发现异常及时上报。团队建设类
14、完成上级主管临时交办的事情。
二、成品出货检验员岗位职责
1、依据相应的《成品检验规范》及相关技术文件对成品进行检验、判定、记录、汇总;
2、发现不合格品时依据验退流程进行操作、并落实处理结果及验证;
3、对客户质量问题的数据统计及汇总;
4、依据相应的《成品检验规范》及相关技术文件对样品进行检验、判定、记录、汇总;
5、参与质量审核相关数据的收集、记录、汇总;
6、上级主管交办的其它事项;
7、配合上级主管的相应调配。
扩展阅读:
20xx年,我在公司各级领导的正确领导下,和同事们的团结合作和关心帮忙下,较好地完成了这一年来的各项工作任务,素质、思想、和人际交往方面都有了更进一步的提高。现将1年来取得的成绩和存在的不足总结如下:
一、品德和个人修养及职业道德方面
一年来,本人认真遵守劳动纪律,按时出勤,有效利用工作时间;坚守岗位,需要加班完成工作按时加班加点,保证工作能按时完成。认真学习知识;具有强烈的职责感。进取主动学习专业知识,工作态度端正,认真负责地对待每一项工作。
二、工作岗位和工作本事方面
我的工作岗位是一名质检员、一个把握工程质量的重要岗位。我深知我的重要性,说以我本着“把工作做的更好”的目标,扎扎实实干好本职工作,并且在工作之余我努力的学习专业知识充实自我,虽然在工作上会遇到很多挫折可是我相信我自我。有句话说得好“从哪里跌倒、就从哪里爬起来”我还很年轻秉着笨鸟先飞的思想,我想信只要我付出的比别人多肯定能泥补我在专业知识上的不足。
三、总结了一年来的工作,以下不足总结
1.是有时工作方面与领导的要求还有必须差距。一方面,由于个人本事和素质不够高,一方面就是工作量多、和时间比...
2017年卫生资格考试再过几个月就要开始了,各位做好备考工作。出国留学网卫生资格考试栏目为大家分享“检验主管技师考点”,希望能帮各位查漏补缺,希望各位考生要抓紧时间复习。
棘形红细胞图片:
棘细胞:红细胞表面有针尖状突起,其间距不规则。突起的长度和宽度不一。在β脂蛋白缺乏症患者的血涂片中出现较多。也可见于脾切除后、酒精中毒性肝脏疾病。注意与皱缩红细胞区别。皱缩红细胞周边呈锯齿形排列紧密、大小相等,外端较尖。

12-15
时间一晃而过,如白隙之间,2012年已接近尾声,回顾自己在刚升为副主管的这一年来的工作,在领导的悉心关怀和指导下,在同事的帮助和鼓励下,通过自身的不懈努力,在工作上取得了一定的成果,但也存在了诸多不足。现就分管的培训工作,向上级领导汇报如下:
一、培训工作情况:
2011年我部与培训部协作共举办了新入职员工消防培训34期,共923人,每届培训合格率达90%以上,基本达到了目标要求;内部员工培训8次(其中包括全公司处置突发事件培训2次,员工消防知识3次,消防实战练习3次,参训人员达245人次。
二、培训工作分析:
1、2011年的培训工作比起2010年相比有了较大的进步,无论是在培训课程还是培训质量上都有了一定的增长幅度。
2、完整了培训计划:建立了制度性培训体系,比起以往的培训工作缺乏制度完善和系统化,培训管理幅度和力度较弱,员工培训意识差,培训工作开展起来较为困难的情形。我部与培训部经过多次沟通,改变了原有的培训模式,将“为什么培训和培训什么”融入到整个公司培训工作中来,在总结了以往的培训经验基础上,优化了培训的重要性,重点加强了培训内容全面性,提升了培训工作的制度化管理。
小编精心推荐
...
xx年,我质检部检验一线全体人员在公司及品管中心的领导下,全力以赴、尽心尽责地做好了产品的检验检测工作,履行了检验员的基本工作职责,为保证全厂的生产正常运转和产品品质控制做了大量的工作,同时保证了质量体系的正常运行,回顾一年来的工作,我们主要从下面几方面做了些工作。
一、 产品的进料检验
1. 原材料质量控制有关产品的生命,我们通过严格把好入口关,从源头来控制产品的质量,对所有外购原料,首先按规定进行报验制度,检验员确认供应商提交的质量证明文件,并从外观、尺寸等方面进行检测,必要时做机械性能方面的检测。
2. 提高检验透明度,产品检验根据检验量的大小,尽快检测,并及时出具检测报告,以方便仓库办理入库手续,增加检验透明度,严格质量检测标准,在满足质量要求的前提下,做到对公司负责的同时,不损害供应商的利益。
小编精心推荐
...
一个人的能力和水平是有限的,只有不断学习才能不但提高,在工作中,我时常感到能力和知识的欠缺,以下是出国留学网小编整理的车间副主管半年工作总结,欢迎参考,更多详细内容请点击出国留学网查看。
尊敬的各位领导、同事:
您们好!我是精四车间的副主管唐x。XX年是公司的团队建设年,上半年工作即将结束。半年来,本车间在公司领导班子和生产部的正确领导下围绕以生产为中心,抓质量,促节能降耗,不断强化车间基础管理工作,狠抓落实。经过全体职工的共同努力,车间的综合管理工作逐步完善,圆满的完成了上级领导下达的各项任务。现将XX年上半年工作总结如下:
一.注重学习,不断提高自身素质,提升工作能力
不论是提高自身素质还是提升工作能力都离不开学习,俗话说活到老学到老,通过不断地学习才能发现自己平时工作中暴露出的问题,从而改善,哪怕是微不足道的细节,天长日久下来也是一笔能够促进工作的财富。培养一支德才兼备的职工队伍一直是车间工作的重点之一。公司在6—8月份开展了3s3p4a培训和7s的推进,在此次活动中车间员工自身素质,工作能力有了大的提高,从而我也看到了团队的不足,但是我不气馁,领导班组人员做好7s工作,按照7s标准,做到现场清洁,物品摆放整齐,地面无杂物,对员工高标准,严要求,对领导下达的任务以结果为导向,坚决执行,绝对服从。促进员工之间更好的团结协作,增强员工的团队意识。上半年也有新员工分配到车间工作,我高度重视,采取了由班组长牵头具体负责的方式,对新工的工作业务技能、安全生产知识等进行岗前操作培训。
二.狠抓现场节能降耗,提高工作质量
企业是我家,维护靠大家,在上半年的工作中,本车间大量的使用了回用的旧外罩、旧锥套、旧吊耳,很好的为公司节约了不少成本。上半年公司因为受大气候的影响,生产任务不是很饱满。越是在这种时候节能降耗工作越是要狠抓。小到节约一度电一滴水,大到爱护公司的设备和原材料。车间在生产的时候,我经常在生产现场进行检查,发现问题及时处理。开班前班后会时,教导员工在工作中要做到人走机停,随手关水,平时保养设备多用心,设备是大家吃饭的工具。只有把员工的利益和公司的利益结合起来才会让员工从心里人认识到设备的重要性。放假期间带领班组长检查门窗。只有以高度的责任感,使命感和积极的工作态度对待工作,才能收获工作中带来的果实,再生产过程中要求员工团结一致地赶任务,任务量大得的时候,以能者多劳的办法,让难度大的活都压在老师傅肩上干,在完成车间本职任务的基础上还协助精一车间加工上下支撑、中轴、支座等工作,确保及时发货,提高了公司的信誉 。
三.抓好班组建设,发挥班组长的骨干带头作用
只有完美的团队,没有完美的个人。为了让每个员工在工作中能积极进取,任劳任怨的干好本职工作,车间采取让每个员工回想以前待过的公司与现在的佳恒对比,然后摆正自己的位置,更好的为公司服务。发挥班组长的骨干带头作用,车间班组长起直接领导带头作用,是重要的纽带和桥梁。车间班组长的工作将直接影响本车间的工作质量和工作任务的完成情况。为了班组长很好的开展工作,每月我都会召开两次以上的班组长会议,将平时工作中发现的问题和情况做详细的分析和讨论,并针对发生的问题和异常情况及时采取紧急措施处理并指导,努力提高班组长的工作能力和应对能力。同时,要...
无论你是从事文员工作,还是从事会计工作;无论你是从事前台工作,还是后勤工作,年度工作总结总是少不了的,它就是你工作中的一部分,你知道怎样进行年度工作总结吗?不知道的话,就来出国留学网吧,下面是小编整理的年度工作总结的相关内容,欢迎大家前来了解。
大家上午好!我叫xxx,是分管xxx保洁工作的副主管。今天,公司召开XX年度保洁工作总结表彰大会,借此机会,向各位领导汇报一下,我在XX年一年的工作情况,对于在工作中发现的问题和不足,请各位领导加以批评和指正。
XX年是不平凡的一年,第29届奥运会在北京顺利召开,使我们感到无比的光荣和自豪。作为保洁员,我们担负着xxx镇各村的环境净化工作,深知自己的责任重大。公司领导及镇村主管环境工作的领导对此极为重视,这就要求我们严格按照公司制定的各项规章制度,认真负责的做好本职工作。
小编精心推荐
...02-04
本文“2017卫生资格检验主管技师考点”,跟着出国留学网卫生从业资格考试频道来了解一下吧。希望能帮到您!
双歧杆菌介绍
双歧杆菌Bifidobacterium是1899年由法国学者Tissier从母乳营养儿的粪便中分离出的一种厌氧的革兰氏阳性杆菌,末端常常分叉,故名双歧杆菌。双歧杆菌分布在胃肠的数量随年龄阶段的增长而减少,分布最多的是母乳营养儿。目前已经发现,双歧杆菌有32个亚型,含有双歧杆菌的生物制剂多达70种。
肌红蛋白
肌红蛋白,分子量为17.5kD,是一个具有153个氨基酸的多肽链和一个含铁血红素辅基组成的亚铁血红素蛋白,存在于骨骼肌和心肌等组织。它能可逆地与氧分子结合,增加氧扩散进入肌细胞的速度。由于骨骼肌和心肌组织中的Mb免疫学性质相同,因此用免疫学方法无法将其分开。近年来随着单克隆技术的发展,建立了荧光酶免法、化学发光法等双抗体夹心法测定Mb,灵敏度达到了ng水平、操作简单,可在数十分钟内完成测定,已越来越广泛地为临床所接受。
参考值:
男性20~80/μg/L
女性10~70μg/L
Cutofflimit::>100μg/L
血清Mb水平随年龄、性别及种族的不同而异,黑人的Mb水平要高于白人。
临床意义:
(1)由于Mb的分子量小,可以很快从破损的细胞中释放出来,在AMI发病后1~3h血中浓度迅速上升,6~7h达峰值,12h内几乎所有AMI患者Mb都有升高,升高幅度大于各心肌酶,因此可以作为AMI的早期诊断标志物。
(2)由于Mb半寿期短(15min),胸痛发作后6~12h不升高,有助于排除AMI的诊断,是筛查AMI很好的指标。
(3)由于在AMI后血中Mb很快从肾脏清除,发病18~30小时内可完全恢复到正常水平。故Mb测定有助于在AMI病程中观察有无再梗死或者梗死再扩展。Mb频繁出现增高,提示原有心肌梗死仍在延续。
(4)Mb是溶栓治疗中判断有无再灌的较敏感而准确的指标。
注意事项:
(1)由于Mb也存在于骨骼肌中,而且仅从肾小球滤液中清除,所以急性肌肉损伤以及各种原因引起的肌病患者、长时间的休克、急性或慢性肾功能不全时Mb都会升高。当Mb作为早期、定量诊断AMI的生化标志物时应除外上列疾病或与之有关的疾病。
(2)不同厂家试剂盒对标本的要求也不同,应按要求取血。如使用抗凝剂,通常采用肝素抗凝。此外,用不同的分析和检测技术所得参考值不同。故各实验室都应建立各自的参考值范围。
(3)由于碳酸酐酶同工酶Ⅲ(carbonicanhydraseⅢ,CAⅢ)不存在于心肌,主要存在于骨骼肌;而其从骨骼肌中的释放模式又和Mb相同,故有人通过Mb/CAⅢ比值来提高Mb诊断AMI的敏感性和特异性,研究表明Mb/CAⅢ于 AMI症状出现2小时后就见升高,敏感性和特异性均比CK和CK-MB高,也是早期心肌损伤的标志物之一。
...01-09
文本“2017检验主管技师辅导资料”由出国留学网卫生资格考试栏目整理,希望对考生有所帮助。
精子的功能检查
精子的功能检查目前应用的是精子低渗肿胀试验(HOS)。
1.检测方法:将精子置入低渗溶液中,由于渗透压改变,精子为维持内外体液间的平衡,水分可通过精子膜进入精子,由于精子尾部的膜更柔软、疏松,所以尾部可肿胀或弯曲。用相差显微镜观察,计算100~200个精子中出现肿胀的百分率。
2.结果判断:a型,未出现肿胀;b型,尾尖肿胀;c型,尾尖弯曲肿胀;d型,尾尖肿胀伴弯曲肿胀;e型,尾弯曲肿胀;f型,尾粗短肿胀;g型,全尾部肿胀。
3.参考值:g型肿胀精子率>50%。
4.临床意义:精子尾部低渗肿胀试验可作为体外精子膜功能及完整性的评估指标,预测精子潜在的受精能力。有研究表明,不育症的精子尾部肿胀率明显减低。
免疫细胞的分离
(1)外周血单个核细胞的分离外周血中单个核细胞(淋巴细胞和单核细胞)的比重与红细胞、多核白细胞及血小板不同,介于1.075~1.090之间,因而可利用一种比重介于1.075~1.092之间而近于等渗的溶液作密度梯度离心,使一定比重的细胞按相应密度梯度分布而加以分离。常用的分层液有Ficoll与Percoll两种。
(2)淋巴细胞的分离1)纯淋巴细胞群的采集:利用单核细胞在37℃和Ca2+存在时,能主动粘附在玻璃、塑料、尼龙毛、棉花纤维或葡聚糖凝胶的特性,从单个核细胞悬液中除去单核细胞,从而获得纯淋巴细胞群。主要的方法有:①粘附贴壁法;②吸附柱过滤法;③磁铁吸引法。
2)淋巴细胞亚群的分离原则:选择纯化所需细胞的方法是阳性选择法,而选择性去除不要的细胞,仅留下所需的细胞为阴性选择法。常用的方法包括:①E花环沉降法;②尼龙毛柱分离法;③亲和板结合分离法;④磁性微球分离法及荧光激活细胞分离仪分离法。
(3)淋巴细胞的保存与活力测定①短期保存技术:短期保存可置于4℃保存。
②长期保存技术:液氮深低温(-196℃)环境保存细胞,加入二甲亚砜作为保护剂。
③活力测定:最简便常用的为台盼蓝染色法,呈蓝色。
卫生资格考试栏目为你推荐:
出货检验副主管推荐访问